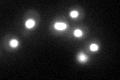
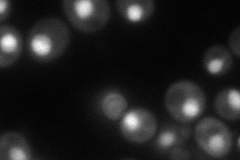
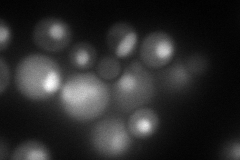
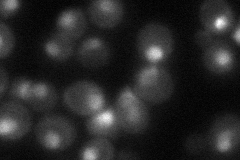

View description
Subunit of a heterodimeric NC2 transcription regulator complex with Bur6p; complex binds to TBP and can repress transcription by preventing preinitiation complex assembly or stimulate activated transcription; homologous to human NC2beta
Localization:
Intensity:
Fold change:
Significance:
-
C’ GFP library in SD
nucleus66.81 -
N' NOP1pr-GFP in SD
nucleus85.0917 -
N' TEF2pr-mCherry in SD
nucleus109.49 -
N' NATIVEpr-GFP in SD
nucleus58.4961 -
N' TEF2pr-VC and Cyto-VN in SD

nucleus39.0885 -
C’ GFP library in SD+DTT

nucleus54.680.81No -
C’ GFP library in SD+H2O2

nucleus63.380.94No -
C’ GFP library in Starvation Media

nucleus82.231.23No -
C’ GFP library on the background of Pup2-DaMP

N/A -
C’ GFP library on the background of CCT mutant

N/A0N/AYes
